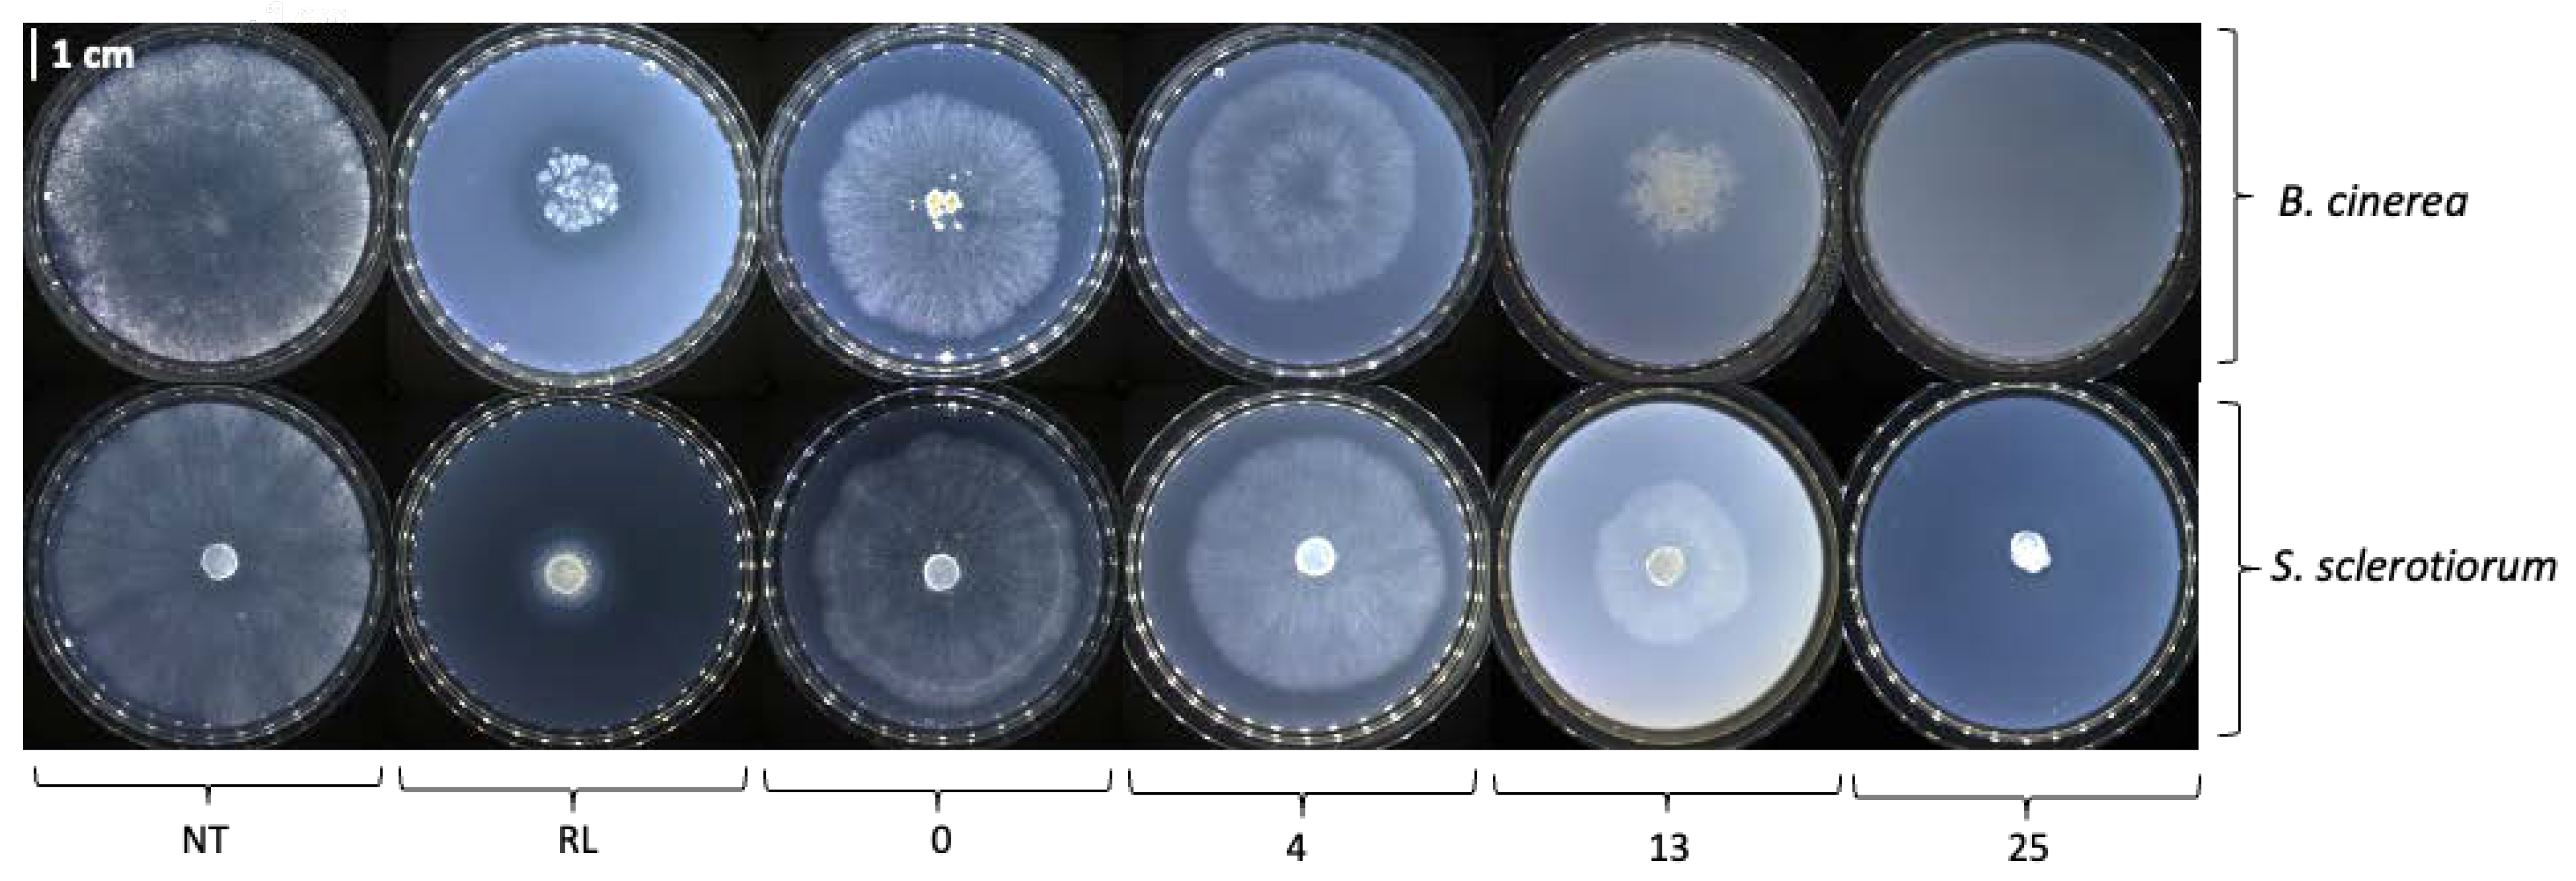
Molecules 28 05803 g0a1 Molecules 28 05803 g0a1

Chemo-Enzymatic Synthesis and Biological Assessment of p-Coumarate Fatty Esters: New Antifungal Agents for Potential Plant Protection
Abstract
1. Introduction
2. Results and Discussion
2.1. Synthesis
2.1.1. Linear Alkyl Coumarate Esters
2.1.2. Ramified Coumarate Esters
2.1.3. Improvement of the Hydrophilicity
Glucosylation
Dihydroxylation
2.2. Biological Activities of p-Coumaric Acid-Based Molecules
2.2.1. Direct In Vitro Antifungal Activity against B. cinerea and S. sclerotiorum
2.2.2. Destabilization of the Plant Plasma Membrane
2.2.3. Arabidopsis Protection against B. cinerea
2.3. Discussion and Perspectives
3. Materials and Methods
3.1. Material
3.2. Methods
3.2.1. Transesterification Pathway (A)
Synthesis of Ethyl Coumarate
General Procedure for Enzymatic Transesterification
3.2.2. Knoevenagel-Doebner Pathway (B)
3.2.3. Synthesis of 13
3.2.4. Glucosylation
3.2.5. Synthesis of Dehydroxylated Alkyl Coumarates
Acetylation
Dihydroxylation and Deacetylation (Pathway C)
Transesterification of Ethyl Dihydroxycoumarate (Pathway D)
3.3. Biological Assays
3.3.1. Growth Conditions of Plant and Fungus Material
3.3.2. In Vitro Antifungal Assay
3.3.3. In Planta Ion Leakage Assay
3.3.4. Plant Protection Assays
4. Conclusions
Author Contributions
Funding
Institutional Review Board Statement
Informed Consent Statement
Data Availability Statement
Conflicts of Interest
Sample Availability
Appendix A

References
- Bi, K.; Liang, Y.; Mengiste, T.; Sharon, A. Killing Softly: A Roadmap of Botrytis Cinerea Pathogenicity. Trends Plant Sci. 2023, 28, 211–222. [Google Scholar] [CrossRef] [PubMed]
- Varnier, A.-L.; Sanchez, L.; Vatsa, P.; Boudesocque, L.; Garcia-Brugger, A.; Rabenoelina, F.; Sorokin, A.; Renault, J.-H.; Kauffmann, S.; Pugin, A.; et al. Bacterial Rhamnolipids Are Novel MAMPs Conferring Resistance to Botrytis Cinerea in Grapevine. Plant Cell Environ. 2009, 32, 178–193. [Google Scholar] [CrossRef] [PubMed]
- Monnier, N.; Furlan, A.; Botcazon, C.; Dahi, A.; Mongelard, G.; Cordelier, S.; Clément, C.; Dorey, S.; Sarazin, C.; Rippa, S. Rhamnolipids From Pseudomonas Aeruginosa are Elicitors Triggering Brassica Napus Protection Against Botrytis Cinerea Without Physiological Disorders. Front. Plant Sci. 2018, 9, 1170. [Google Scholar] [CrossRef] [PubMed]
- Ding, L.-N.; Li, T.; Guo, X.-J.; Li, M.; Liu, X.-Y.; Cao, J.; Tan, X.-L. Sclerotinia Stem Rot Resistance in Rapeseed: Recent Progress and Future Prospects. J. Agric. Food Chem. 2021, 69, 2965–2978. [Google Scholar] [CrossRef] [PubMed]
- Jacometti, M.A.; Wratten, S.D.; Walter, M. Management of Understorey to Reduce the Primary Inoculum of Botrytis Cinerea: Enhancing Ecosystem Services in Vineyards. Biol. Control 2007, 40, 57–64. [Google Scholar] [CrossRef]
- Crouzet, J.; Arguelles-Arias, A.; Dhondt-Cordelier, S.; Cordelier, S.; Pršić, J.; Hoff, G.; Mazeyrat-Gourbeyre, F.; Baillieul, F.; Clément, C.; Ongena, M.; et al. Biosurfactants in Plant Protection Against Diseases: Rhamnolipids and Lipopeptides Case Study. Front. Bioeng. Biotechnol. 2020, 8, 1014. [Google Scholar] [CrossRef]
- Falardeau, J.; Wise, C.; Novitsky, L.; Avis, T.J. Ecological and Mechanistic Insights into the Direct and Indirect Antimicrobial Properties of Bacillus Subtilis Lipopeptides on Plant Pathogens. J. Chem. Ecol. 2013, 39, 869–878. [Google Scholar] [CrossRef]
- Robineau, M.; Le Guenic, S.; Sanchez, L.; Chaveriat, L.; Lequart, V.; Joly, N.; Calonne, M.; Jacquard, C.; Declerck, S.; Martin, P.; et al. Synthetic Mono-Rhamnolipids Display Direct Antifungal Effects and Trigger an Innate Immune Response in Tomato against Botrytis Cinerea. Molecules 2020, 25, 3108. [Google Scholar] [CrossRef]
- Dewen, Q.; Yijie, D.; Yi, Z.; Shupeng, L.; Fachao, S. Plant Immunity Inducer Development and Application. Mol. Plant-Microbe Interact. 2017, 30, 355–360. [Google Scholar] [CrossRef]
- Smith, J.M.; Heese, A. Rapid Bioassay to Measure Early Reactive Oxygen Species Production in Arabidopsis Leave Tissue in Response to Living Pseudomonas Syringae. Plant Methods 2014, 10, 6. [Google Scholar] [CrossRef]
- Yuan, M.; Ngou, B.P.M.; Ding, P.; Xin, X.-F. PTI-ETI Crosstalk: An Integrative View of Plant Immunity. Curr. Opin. Plant Biol. 2021, 62, 102030. [Google Scholar] [CrossRef] [PubMed]
- Monnier, N.; Furlan, A.L.; Buchoux, S.; Deleu, M.; Dauchez, M.; Rippa, S.; Sarazin, C. Exploring the Dual Interaction of Natural Rhamnolipids with Plant and Fungal Biomimetic Plasma Membranes through Biophysical Studies. Int. J. Mol. Sci. 2019, 20, 1009. [Google Scholar] [CrossRef]
- Rodríguez-Moraga, N.; Ramos-Martín, F.; Buchoux, S.; Rippa, S.; D’Amelio, N.; Sarazin, C. The Effect of Rhamnolipids on Fungal Membrane Models as Described by Their Interactions with Phospholipids and Sterols: An in Silico Study. Front. Chem. 2023, 11, 1124129. [Google Scholar] [CrossRef]
- Schellenberger, R.; Touchard, M.; Clément, C.; Baillieul, F.; Cordelier, S.; Crouzet, J.; Dorey, S. Apoplastic Invasion Patterns Triggering Plant Immunity: Plasma Membrane Sensing at the Frontline. Mol. Plant Pathol. 2019, 20, 1602–1616. [Google Scholar] [CrossRef]
- Schellenberger, R.; Crouzet, J.; Nickzad, A.; Kutschera, A.; Gerster, T.; Borie, N.; Dawid, C.; Cloutier, M.; Villaume, S.; Dhondt-cordelier, S.; et al. Rhamnolipids and Their 3-(3-Hydroxyalkanoyloxy)Alkanoic Acid Precursors Activate Arabidopsis Innate Immunity through Two Independent Mechanisms. Proc. Natl. Acad. Sci. USA 2021, 118, e2101366118. [Google Scholar] [CrossRef] [PubMed]
- Islam, M.T.; Lee, B.R.; Das, P.R.; La, V.H.; Jung, H.i.; Kim, T.H. Characterization of P-Coumaric Acid-Induced Soluble and Cell Wall-Bound Phenolic Metabolites in Relation to Disease Resistance to Xanthomonas Campestris Pv. Campestris in Chinese Cabbage. Plant Physiol. Biochem. 2018, 125, 172–177. [Google Scholar] [CrossRef] [PubMed]
- Mussatto, S.I.; Dragone, G.; Roberto, I.C. Ferulic and P-Coumaric Acids Extraction by Alkaline Hydrolysis of Brewer’s Spent Grain. Ind. Crops Prod. 2007, 25, 231–237. [Google Scholar] [CrossRef]
- Flourat, A.L.; Combes, J.; Bailly-Maitre-Grand, C.; Magnien, K.; Haudrechy, A.; Renault, J.; Allais, F. Accessing p-Hydroxycinnamic Acids: Chemical Synthesis, Biomass Recovery, or Engineered Microbial Production? ChemSusChem 2021, 14, 118–129. [Google Scholar] [CrossRef] [PubMed]
- Rodriguez, A.; Kildegaard, K.R.; Li, M.; Borodina, I.; Nielsen, J. Establishment of a Yeast Platform Strain for Production of P-Coumaric Acid through Metabolic Engineering of Aromatic Amino Acid Biosynthesis. Metab. Eng. 2015, 31, 181–188. [Google Scholar] [CrossRef]
- Combes, J.; Imatoukene, N.; Moussa, M.; Coquart, N.; Chemarin, F.; Athès, V.; Fojcik, C.; Chadni, M.; Ioannou, I.; Lopez, M.; et al. In-Stream Product Recovery of p-Coumaric Acid Heterologously Produced: Implementation of a Continuous Liquid-Liquid Extraction Assisted by Hollow Fiber Membrane Contactor. Sep. Purif. Technol. 2022, 293, 121083. [Google Scholar] [CrossRef]
- Platel, R.; Chaveriat, L.; Le Guenic, S.; Pipeleers, R.; Magnin-Robert, M.; Randoux, B.; Trapet, P.; Lequart, V.; Joly, N.; Halama, P.; et al. Importance of the C12 Carbon Chain in the Biological Activity of Rhamnolipids Conferring Protection in Wheat against Zymoseptoria Tritici. Molecules 2021, 26, 40. [Google Scholar] [CrossRef]
- Pion, F.; Reano, A.F.; Ducrot, P.; Allais, F. Chemo-Enzymatic Preparation of New Bio-Based Bis- and Trisphenols: New Versatile Building Blocks for Polymer Chemistry. RSC Adv. 2013, 3, 8988. [Google Scholar]
- Hollande, L.; Domenek, S.; Allais, F. Chemo-Enzymatic Synthesis of Renewable Sterically-Hindered Phenolic Antioxidants with Tunable Polarity from Lignocellulose and Vegetal Oil Components. Int. J. Mol. Sci. 2018, 19, 3358. [Google Scholar] [CrossRef]
- Fadlallah, S.; Peru, A.A.M.; Longé, L.; Allais, F. Chemo-Enzymatic Synthesis of a Levoglucosenone-Derived Bi-Functional Monomer and Its Ring-Opening Metathesis Polymerization in the Green Solvent CyreneTM. Polym. Chem. 2020, 11, 7471–7475. [Google Scholar] [CrossRef]
- Peyrot, C.; Peru, A.A.M.; Mouterde, L.M.M.; Allais, F. Proline-Mediated Knoevenagel-Doebner Condensation in Ethanol: A Sustainable Access to p-Hydroxycinnamic Acids. ACS Sustain. Chem. Eng. 2019, 7, 9422–9427. [Google Scholar] [CrossRef]
- Rioux, B.; Peyrot, C.; Mention, M.M.; Brunissen, F.; Allais, F. Sustainable Synthesis of P-Hydroxycinnamic Diacids through Proline-Mediated Knoevenagel Condensation in Ethanol: An Access to Potent Phenolic UV Filters and Radical Scavengers. Antioxidants 2020, 9, 331. [Google Scholar] [CrossRef]
- Reano, A.F.; Chérubin, J.; Peru, A.M.M.; Wang, Q.; Clément, T.; Domenek, S.; Allais, F. Structure-Activity Relationships and Structural Design Optimization of a Series of p-Hydroxycinnamic Acids-Based Bis-and Trisphenols as Novel Sustainable Antiradical/Antioxidant Additives. ACS Sustain. Chem. Eng. 2015, 3, 3486–3496. [Google Scholar] [CrossRef]
- Bonnaud, L.; Chollet, B.; Dumas, L.; Peru, A.A.M.; Flourat, A.L.; Allais, F.; Dubois, P. High-Performance Bio-Based Benzoxazines from Enzymatic Synthesis of Diphenols. Macromol. Chem. Phys. 2019, 220, 1800312. [Google Scholar] [CrossRef]
- Peyrot, C.; Mention, M.M.; Brunissen, F.; Allais, F. Sinapic Acid Esters: Octinoxate Substitutes Combining Suitable Uv Protection and Antioxidant Activity. Antioxidants 2020, 9, 782. [Google Scholar] [CrossRef]
- Ferrari, E.; Lazzari, S.; Marverti, G.; Pignedoli, F.; Spagnolo, F.; Saladini, M. Synthesis, Cytotoxic and Combined CDDP Activity of New Stable Curcumin Derivatives. Bioorg. Med. Chem. 2009, 17, 3043–3052. [Google Scholar] [CrossRef]
- Merlani, M.; Barbakadze, V.; Amiranashvili, L.; Gogilashvili, L.; Poroikov, V.; Petrou, A.; Geronikaki, A.; Ciric, A.; Glamoclija, J.; Sokovic, M. New Caffeic Acid Derivatives as Antimicrobial Agents: Design, Synthesis, Evaluation and Docking. Curr. Top. Med. Chem. 2019, 19, 292–304. [Google Scholar] [CrossRef] [PubMed]
- Moreaux, M.; Bonneau, G.; Peru, A.; Brunissen, F.; Janvier, M.; Haudrechy, A.; Allais, F. High-Yielding Diastereoselective Syn-Dihydroxylation of Protected HBO: An Access to D-(+)-Ribono-1,4-Lactone and 5-O-Protected Analogues. Eur. J. Org. Chem. 2019, 2019, 1600–1604. [Google Scholar] [CrossRef]
- Chen, J.; Bao, S.; Fang, Y.; Wei, L.; Zhu, W.; Peng, Y.; Fan, J. An LRR-only Protein Promotes NLP-triggered Cell Death and Disease Susceptibility by Facilitating Oligomerization of NLP in Arabidopsis. New Phytol. 2021, 232, 1808–1822. [Google Scholar] [CrossRef]
- Zhou, P.; Wang, X.; Yang, B.; Hollmann, F.; Wang, Y. Chemoenzymatic Epoxidation of Alkenes with Candida Antarctica Lipase B and Hydrogen Peroxide in Deep Eutectic Solvents. RSC Adv. 2017, 7, 12518–12523. [Google Scholar] [CrossRef]
- Aguilera, A.F.; Lindroos, P.; Rahkila, J.; Klimov, M.M.; Tolvanen, P.; Salmi, T. Lipase Catalyzed Green Epoxidation of Oleic Acid Using Ultrasound as a Process Intensification Method. Chem. Eng. Process. Process Intensif. 2022, 174, 108882. [Google Scholar] [CrossRef]
- Bataille, C.J.R.; Donohoe, T.J. Osmium-Free Direct Syn-Dihydroxylation of Alkenes. Chem. Soc. Rev. 2011, 40, 114–128. [Google Scholar] [CrossRef] [PubMed]
- Wei, J.; Wu, L.; Wang, H.X.; Zhang, X.; Tse, C.W.; Zhou, C.Y.; Huang, J.S.; Che, C.M. Iron-Catalyzed Highly Enantioselective Cis-Dihydroxylation of Trisubstituted Alkenes with Aqueous H2O2. Angew. Chem. Int. Ed. 2020, 59, 16561–16571. [Google Scholar] [CrossRef]
- Gally, C.; Nestl, B.M.; Hauer, B. Engineering Rieske Non-Heme Iron Oxygenases for the Asymmetric Dihydroxylation of Alkenes. Angew. Chem. 2015, 127, 13144–13148. [Google Scholar] [CrossRef]
- Heinemann, P.M.; Armbruster, D.; Hauer, B. Active-Site Loop Variations Adjust Activity and Selectivity of the Cumene Dioxygenase. Nat. Commun. 2021, 12, 1095. [Google Scholar] [CrossRef]
- Cordelier, S.; Crouzet, J.; Gilliard, G.; Dorey, S.; Deleu, M.; Dhondt-Cordelier, S. Deciphering the Role of Plant Plasma Membrane Lipids in Response to Invasion Patterns: How Could Biology and Biophysics Help? J. Exp. Bot. 2022, 73, 2765–2784. [Google Scholar] [CrossRef]
- Bigeard, J.; Colcombet, J.; Hirt, H. Signaling Mechanisms in Pattern-Triggered Immunity (PTI). Mol. Plant 2015, 8, 521–539. [Google Scholar] [CrossRef] [PubMed]
- Aerts, N.; Pereira Mendes, M.; Van Wees, S.C.M. Multiple Levels of Crosstalk in Hormone Networks Regulating Plant Defense. Plant J. 2021, 105, 489–504. [Google Scholar] [CrossRef] [PubMed]
- Zhou, J.-M.; Zhang, Y. Plant Immunity: Danger Perception and Signaling. Cell 2020, 181, 978–989. [Google Scholar] [CrossRef] [PubMed]
- Nascimento, S.B.; Lima, A.M.; Borges, B.N.; de Souza, C.R.B. Endophytic Bacteria from Piper Tuberculatum Jacq.: Isolation, Molecular Characterization, and in Vitro Screening for the Control of Fusarium Solani f. Sp Piperis, the Causal Agent of Root Rot Disease in Black Pepper (Piper nigrum L.). Genet. Mol. Res. 2015, 14, 7567–7577. [Google Scholar] [CrossRef]








| Supplier | Products |
|---|---|
| TCI (Tokyo Chemical Industry), (Zwijndrecht, Belgium) | p-coumaric acid; 1-nonanol; 1-undecanol; 1-tridecanol; 2-butyloctan-1-ol; 2-hexyldecan-1-ol; 2-octyldodecan-1-ol; 2,2-diméthyl-1,3-dioxane-4,6-dione (Meldrum’s acid); decanoic acid; 1,2-decanediol; N-methylmorpholine N-oxide (aqueous solution 50%); and diethyl malate |
| Sigma-Aldrich (Saint Quentin Fallavier, France) | 1-decanol, Amberlyst IR120, lactic acid (85% in water), ethyl L-lactate, diethyl L-tartrate, and 3-hydroxypropionic acid (30% in water) |
| Acros Organics (Illkirch, France) | 4-hydroxybenzaldehyde, 1-dodecanol, 1-tetradecanol, L-proline, pyridine, aniline, piperazine, and sodium methanoate |
| VWR Chemicals (Rosny-sous-Bois, France) | 1-octanol, citric acid, acetic anhydride and solvents |
| Fisher Scientific (Illkirch, France) | HCl (37%); and 1-bromo-2,3,4,6-tetracetyl-α-D-glucopyranosyl |
| Alfa Aesar (Kandel, Germany) | Glycerol |
| Strem Chemicals (Bischeim France) | Potassium osmate (K2OsO4) |
| Carbosynth (Compton, UK) | D/L-glyceric acid (20% in water) |
| Univar Food ingredients (Mitry-Mory, France) | Novozym 435 (lipase B from Candida antarctica) |
| Eurisotop (Saint-Aubin, France) | Deuterated solvents (CDCl3, acetone-d6, CD3OD) |
| Molecule | 2 | 3 | 4 | 5 | 6 | 7 | 8 | 9 | 10 | 11 |
|---|---|---|---|---|---|---|---|---|---|---|
| Yield (%) by pathway A | 58 | n.d. | 64 | n.d. | 77 | n.d. | 58 | n.r. | n.r. | n.r. |
| Yield (%) by pathway B | n.d. | 40 | n.d. | 53 | 72 | 44 | 43 | 46 | 33 | 42 |
| Molecule | 25 | 26 | 27 | 28 | 29 |
|---|---|---|---|---|---|
| Yield (%) by pathway C | 69 | 55 | 50 | n.d. | 55 |
| Yield (%) by pathway D | n.d. | 68 | 85 | 65 | 40 |
Disclaimer/Publisher’s Note: The statements, opinions and data contained in all publications are solely those of the individual author(s) and contributor(s) and not of MDPI and/or the editor(s). MDPI and/or the editor(s) disclaim responsibility for any injury to people or property resulting from any ideas, methods, instructions or products referred to in the content. |
© 2023 by the authors. Licensee MDPI, Basel, Switzerland. This article is an open access article distributed under the terms and conditions of the Creative Commons Attribution (CC BY) license (https://creativecommons.org/licenses/by/4.0/).
Share and Cite
Thaeder, C.; Stanek, J.; Couvreur, J.; Borrego, C.; Brunissen, F.; Allais, F.; Flourat, A.L.; Cordelier, S. Chemo-Enzymatic Synthesis and Biological Assessment of p-Coumarate Fatty Esters: New Antifungal Agents for Potential Plant Protection. Molecules 2023, 28, 5803. https://doi.org/10.3390/molecules28155803
Thaeder C, Stanek J, Couvreur J, Borrego C, Brunissen F, Allais F, Flourat AL, Cordelier S. Chemo-Enzymatic Synthesis and Biological Assessment of p-Coumarate Fatty Esters: New Antifungal Agents for Potential Plant Protection. Molecules. 2023; 28(15):5803. https://doi.org/10.3390/molecules28155803
Chicago/Turabian StyleThaeder, Cyrian, Juliette Stanek, Julien Couvreur, Célia Borrego, Fanny Brunissen, Florent Allais, Amandine L. Flourat, and Sylvain Cordelier. 2023. "Chemo-Enzymatic Synthesis and Biological Assessment of p-Coumarate Fatty Esters: New Antifungal Agents for Potential Plant Protection" Molecules 28, no. 15: 5803. https://doi.org/10.3390/molecules28155803
APA StyleThaeder, C., Stanek, J., Couvreur, J., Borrego, C., Brunissen, F., Allais, F., Flourat, A. L., & Cordelier, S. (2023). Chemo-Enzymatic Synthesis and Biological Assessment of p-Coumarate Fatty Esters: New Antifungal Agents for Potential Plant Protection. Molecules, 28(15), 5803. https://doi.org/10.3390/molecules28155803

